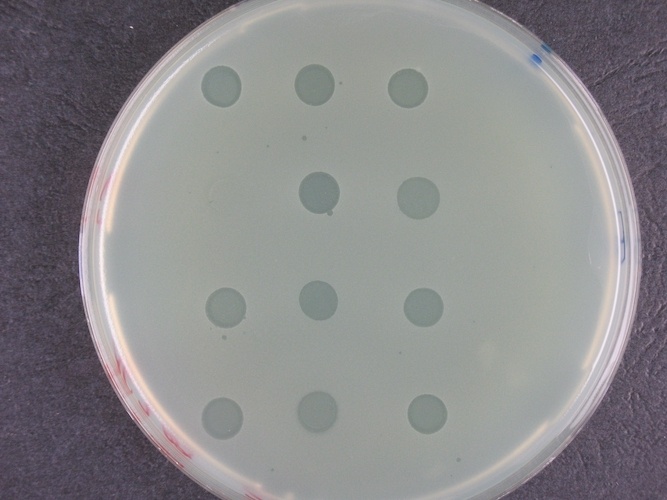
Bakterienrasen mit Löchern, die durch Phagen verursacht werden Foto: DSMZ

Viren, die Krankheiten bekämpfen können: Bakteriophagen
Seit 30 Jahren forscht Dr. Christine Rohde am Leibniz-Institut DSMZ an Bakteriophagen, die als intelligente Antibiotika bezeichnet werden.
Das Leibniz-Institut DSMZ-Deutsche Sammlung von Mikroorganismen und Zellkulturen in Braunschweig befasst sich seit über 30 Jahren mit Bakteriophagen – kurz Phagen - und integrierte die in der Grundlagenforschung bekanntesten in die Deutsche Phagenbank. Eine längere Zeit verbrachten die Phagen in der DSMZ eher „wartend", erläutert die renommierte DSMZ-Phagenforscherin Dr. Christine Rohde. Das Nutzungspotenzial für die Medizin wurde in der westlichen Welt erst artikuliert, als die Antibiotikakrise als Stichwort in der ersten Dekade dieses Jahrhunderts immer häufiger auftrat.
Phagen (aus dem Griechischen: Bakterienfresser) sind die häufigste Daseinsform auf unserem Planeten, so Dr. Rohde. Phagen sind Viren, die Bakterien spezifisch zerstören können. Die Weltgesundheitsorganisation WHO veröffentlichte im Jahr 2014 den ersten umfassenden globalen Surveillance Report. Dieser Report verdeutlichte das erschreckende Ausmaß der Verbreitung multiresistenter Bakterien (Antimikrobielle Resistenz = AMR) und die zu erwartenden, mittlerweile bekannten, Szenarien der wachsenden AMR-bedingten Sterblichkeitsraten, der Kostenexplosion im Gesundheitssystem und der Umweltschädigung durch Einbringung von AMR in die Tiermast.
Die Zeitschiene der Phagen-Ära spiegelt sich in der Sammlung der DSMZ: Um 2005 wurden die Phagen häufiger auf Kongressen thematisiert, ab 2010 kamen die ersten Journalistenanfragen und Artikel zum Thema Phagen als Antibiotika-Alternative, informiert Dr. Rohde. Zum Durchbruch in der Öffentlichkeit in Deutschland kam es im Jahr 2012 durch Artikel in populären Printmedien und durch die erste TV-Sendung mit DSMZ-Beteiligung. Seither ist das Interesse an Phagentherapie bei Patienten und Ärzten stark gestiegen. Die DSMZ weitete in Folge dessen ihre Forschungskapazitäten durch die Etablierung der Arbeitsgruppe Phagengenomik und -anwendung unter der Leitung von Dr. Johannes Wittmann aus. Zusammen mit der Arbeitsgruppe Klinische Phagen und gesetzliche Regulation, geleitet von Dr. Christine Rohde, bildet sie das Fundament der Phagenforschung an der DSMZ.
Antimikrobielle Resistenz im Fokus der Forschung
AMR-Forschung adressiert neben der Suche nach neuen Antibiotika auch Bakteriophagen als Ergänzung oder Ersatz von Antibiotika. Phagen werden im Gegensatz zu den „statischen Drogen/Substanzen“ auch „intelligente Antibiotika“ genannt. Sie sind die natürlichen Gegenspieler der Bakterien und können da eingesetzt werden, wo Bakterien unerwünscht sind, also als Antiinfektiva in der Medizin. Phagen vermehren sich am Infektionsort, solange ihre passenden „Beutebakterien“ vorhanden sind und zerfallen danach wieder in ihre Bausteine (Protein und Nukleinsäure). Damit sind sie selbst-regulierende Antiinfektiva, die zudem spezifisch wirken. Ein Phage kann spezifisch nur Bakterien einer Art erkennen und zerstören.
„Jeder Mensch trägt eine Unmenge an Phagen in seinem Mikrobiom.“ erläutert Johannes Wittmann. Diese Phagen im menschlichen Organismus - das Phagom - übersteigen die Zahl der Bakterien im menschlichen Organismus vermutlich um das Zehnfache. Erkrankt man an einer bakteriellen Infektion und wendet Phagen anstelle von Antibiotika an, verschiebt man im Grunde in der Erkrankung nur das Gleichgewicht zugunsten der passenden Phagen, um den Überschuss der pathogenen Bakterien zu minimieren oder zu eradizieren (eliminieren). Phagen haben demzufolge ein großes Potenzial in der AMR-Forschung und können gegen fast alle Bakterien mit Ausnahme derer, die einen intrazellulären Lebenszyklus haben, eingesetzt werden. Dazu gehören beispielsweise die Erreger der Borreliose oder der Tuberkulose.
Wo steht die Phagenforschung und wie sieht die Zukunft aus?
Nach einer intensiven Vorbereitungsphase startete am Leibniz-Institut DSMZ im September 2017 mit öffentlicher BMBF-Finanzierung Phage4Cure als erstes deutsches Projekt mit dem Ziel einer klinischen Studie, in der ein hochaufgereinigter Phagencocktail inhalativ bei Patienten mit Bronchiektasen und Mukoviszidose eingesetzt werden soll. In Phage4Cure hat die DSMZ die Rolle des Forschungs- und Entwicklungsanteils der Phagenbiologie inne, der im geplanten Zeitfenster innerhalb eines Jahres abgeschlossen werden konnte. In diesem Pilotprojekt zeigt sich die Komplexität einer klinischen Studie mit arzneimittelrechtlicher Herstellung: Phagen als API (aktiver pharmazeutischer Inhaltsstoff) und dem Zulassungsprozess durch BfArM (Bundesinstitut für Arzneimittel und Medizinprodukte), mit präklinischem Teil und schließlich der Erprobung an gesunden Probanden. Zurzeit befinden sich die Phagen in der finalen GMP-Herstellung (GMP = Good Manufacturing Processes) im Fraunhofer ITEM Braunschweig. Die Präklinik läuft in Kürze im Fraunhofer ITEM Hannover und in der Charité Universitätsmedizin Berlin an, wo auch die klinische Studie stattfinden wird, zusammen mit der CRO GmbH, erläutert Phagenforscherin Rohde.
Ein weiteres öffentlich gefördertes Projekt mit Finanzierung durch den Gemeinsamen Bundesausschuss und dem Ziel der Phagentherapie ist PhagoFlow: Hier sollen im Gegensatz zu einer klinischen Studie größere Zahlen verschiedener Phagen für Patienten mit Wunden der unteren Extremität in magistraler Anwendung verfügbar werden. Die größere Phagen-Diversität soll dazu beitragen, für Patienten passgenau individuelle Phagencocktails in der Klinikapotheke des Bundeswehrkrankenhauses (BW-KrHs) Berlin zu mischen. Das vorherige „Phagogramm" wird in der Labordiagnostik des BW-KrHs zeigen, welche Phagen aus dem Sortiment bei einem Patienten-Keim passen. PhagoFlow hat das Ziel, Phagen in die Versorgungsforschung zu bringen. Auch hier bearbeitet die DSMZ den Projektanteil der Phagenbiologie und der Selektion der bestgeeigneten Phagen, die am Fraunhofer ITEM Braunschweig aufgereinigt und der Klinikapotheke des BW-KrHs weitergegeben werden. Die klinische Anwendung findet im BW-KrHs statt, informiert Dr. Rohde.
Zwei weitere, durch industrielle Drittmittel finanzierte Phagentherapie-Projekte sind erfolgreich an der DSMZ abgeschlossen. Eines davon, mit einem deutschen Industriepartner, hat das Ziel, nach BfArM-Zulassung ein Phagenprodukt herzustellen, das denselben Zulassungsweg inklusive klinischer Studie beinhaltet wie Phage4Cure. Das andere Projekt ist zur Zeit noch deutlich forschungsgetrieben. Es ist charakterisiert durch mehrgleisige Teilprojekte und hat namhafte Projektbeteiligte aus Medizin und Forschung im In- und Ausland. Trotz der bisherigen ermutigenden Erfolgsrate bei der Bewilligung der genannten Drittmittel-Anträge des Leibniz-Instituts DSMZ sind in der Realität der Vorhaben doch die langen Zeiträume des Zulassungsweges und die Komplexität der Projekte deutlich. Phagen als lebende Entitäten brauchen an manchen Stellen im Zulassungsprozess andere Betrachtungsweisen. Zum Teil sind sie aber einfacher: toxisch, mutagen, kanzerogen oder fruchtschädigend sollten sie nicht sein, dazu kennt unser Organismus diese häufigsten Daseinsformen viel zu gut und beherbergt sie als Regulativ im eigenen Mikrobiom. „Es ist sichtbar geworden, dass der Zulassungsweg für Phagen zügiger sein sollte, dabei ist nicht bekannt, ob im Sinne von top-down ein von vornherein harmonisierter europäischer Prozess auf EMA-Ebene gewünscht ist oder eine bottom-up nationale Strategie, die am Ende auf EMA-Ebene harmonisiert werden soll (EMA = European Medicines Agency).“ erläutert Rohde.
Phagenforschung an der DSMZ während der Corona-Pandemie
Wir befinden uns mitten in der COVID-19-Pandemie und mittlerweile wird die Pathogenese des SARS-CoV-2-Virus besser verstanden. „Bei allen auf das Virus fokussierten Anstrengungen darf die Antibiotikakrise aber gerade jetzt nicht aus den Augen verloren werden, denn an COVID-19 erkrankte Patienten erleiden leicht eine bakterielle Sekundärinfektion.“, macht Dr. Christine Rohde deutlich. Das ist umso dramatischer, denn wenn die verabreichten Antibiotika nicht mehr wirken, können Krankheitsverläufe unter solchen Ko-Infektionen verschlimmert werden. In einer retrospektiven COVID-19-Patienten-Kohortenstudie Ende März in Wuhan zu den Risikofaktoren, die bei COVID-19 bedingten Todesfällen auftraten, wird berichtet, dass 91 % der klinischen Patienten Antibiotika erhielten (The Lancet 395).
Anbieter













